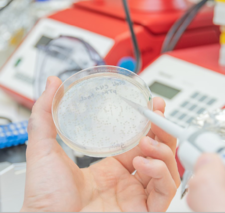
Projekte_und_Programme2.png

Forschung
"Neues gesundheitsbezogenes Wissen schaffen und zum Wohle der Menschen und der Gesellschaft anwenden - diese in Greifswald seit über 560 Jahren geltende Maxime liegt auch in den kommenden Jahren den Forschungsideen und -Vorhaben der Wissenschaftler*innen der UMG zugrunde."

Forschungsleistungen
Publikationen und Drittmittelausgaben
Neues aus der Wissenschaft
An dieser Stelle berichten wir aus dem Bereich Wissenschaftskommunikation:
- Pressemitteilungen
- Besondere Leistungen in der Forschung
- Neue Projekte stellen sich vor
- Very important Publications
finden Sie hier
Forschungsprofil
Kennzeichen des Forschungsprofils der Universitätsmedizin Greifswald sind die komplementäre Verknüpfung der Schwerpunkte Community Medicine und Molekulare Medizin und der daraus resultierende Greifswalder Ansatz einer individualisierten Medizin. Mit diesen Schwerpunkten besitzt die UMG die Werkzeuge, nicht nur relevante Ergebnisse in der Grundlagen-, der epidemiologischen, der klinischen und Versorgungsforschung zu erzielen, sondern diese Ergebnisse auch in die Gesundheitsversorgung zu übersetzen.
Seit 2021 wird dieser Dreiklang noch ergänzt durch den Schwerpunkt Digital Health - die Digitalisierung medizinischer Versorgungsdaten, digitale Technologien wie Entscheidungsunterstützungssysteme sowie Methoden der künstlichen Intelligenz (KI) werden die medizinische Versorgung und Gesundheitswirtschaft grundlegend verändern und immer mehr beeinflussen.
Ein Forschungsfokus, der in Zukunft weiter ausgebaut werden soll auf dieser Basis, ist die Prävention. Es soll ein integrierter und ganzheitlicher Ansatz zur Krankheitsprävention entwickelt werden, der die verschiedenen Disziplinen durch gemeinsame, übergreifende und zentrale Forschungsfragen zusammenführt und ausrichtet.

- Community Medicine
- Molekulare Medizin
- Individualisierte Medizin
- Digital Health
- Prävention
- Infektion und Entzündung
- Herz-Kreislauf Erkrankungen
- Neurologische und psychische Erkrankungen
- Krebs
Wissenschaftsstandort Greifswald
Am Standort Greifswald sind neben Universität und Universitätsmedizin fünf international renommierte außeruniversitäre Forschungseinrichtungen angesiedelt, die im engen Austausch miteinander die Forschungslandschaft im Nordosten Deutschlands prägen: Das Helmholtz Institut für One Health (HIOH), das Friedrich-Löffler-Institut (FLI), Leibniz-Institut für Plasmaforschung und Technologie (INP), Max-Planck-Institut für Plasmaphysik (IPP) und das Alfried Krupp Wissenschaftskolleg. Übergreifende Forschungsschwerpunkte sind One Health und Plasmaphysik.
Forschungsprofil der Universität Greifswald
Die Universität Greifswald zeichnet sich durch exzellente Grundlagen- und anwendungsbezogene Forschung aus. Die Forschungsschwerpunkte, die in einigen Bereichen eng mit der Universitätsmedizin vernetzt sind, liegen in den Bereichen One Health und Life Sciences, Forschung zum Ostseeraum sowie Prävention und Community Medicine. Neben der Vielfalt ihrer Disziplinen und der daraus resultierenden Stärke interdisziplinärer Forschung unterhält die Universität enge Kooperationen mit den außeruniversitären Wissenschaftseinrichtungen am Standort Greifswald und darüber hinaus.
Verknüpfung von Geisteswissenschaften und Medizin
Die enge Verbindung der fünf Fakultäten der Universität Greifwald ermöglicht die Betrachtung komplexer Themengebiete aus verschiedenen Positionen und unter Einbeziehung zahlreicher Expertisen. Medizinische Themen werden nicht allein naturwissenschaftlich betrachtet, sondern transdisziplinär im Austausch mit Geistes-, Sozial- und Verhaltenswissenschaften. In Greifswald existieren zwei Netzwerke, die den Austausch zwischen den Disziplinen unterstützen und sich dem weiten Themenfeld Medizin aus verschiedensten Richtungen nähern: